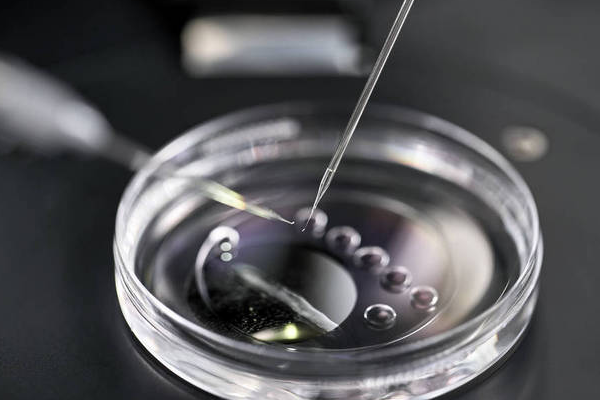
8b0cabe1d60bd022ed7516e1fe9f1cf8.png 深圳冻卵费用是多少

深圳是中国现代化程度较高的城市之一,也是许多女性选择冻卵的热门地区。对于那些希望保留生育能力的女性来说,深圳的各大医院提供了专业的冻卵服务。下面将介绍一些在深圳有良好口碑的冻卵医院以及相关费用信息,帮助有需要的女性更好地了解和选择合适的冻卵医疗机构。
深圳冻卵哪家医院?
4.深圳市罗湖区人民医院
5.深圳中山泌尿外科医院
冷冻卵子技术是一种属于人类辅助生殖技术的方法。虽然深圳市有多家医院可以进行辅助生殖技术,并且已经成功实施了冷冻卵子的案例,但是冷冻卵子仍然有严格的医学适应症。建议患者前往深圳的这些辅助生殖医院进行具体咨询,以便了解更详细的信息。

深圳冻卵费用是多少?
在深圳地区,促排卵加首次冷冻卵子的费用一般约为2万元左右。然而,不同公立医院和私立医院的收费可能存在一定差异,价格可能在3-4万元之间。
此外,由于患者的个体情况各异,收费标准也会有所不同。因此,最好咨询医院以确定具体的冷冻卵子费用。尽管国内的冷冻卵子技术可以满足一定需求,但并非所有女性都必须进行冷冻卵子。具体是否需要冷冻卵子应根据家庭和个人实际情况做出决策。
试管邦温馨提示:需要强调的是,具体的深圳冻卵医院和费用问题应咨询相关医院或专业人士以获取准确的信息。每个医院的服务项目、设施条件和价格标准可能存在差异,因此选择时要综合考虑自身需求和经济实力,并与医生进行充分沟通和咨询。找到一家值得信赖的医院,并获得专业的冻卵指导和贴心的护理,这样能为女性提供更多的安全和保障,实现她们的生育计划。
